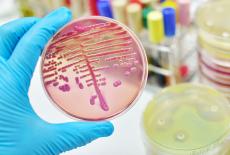
Septicemia

Infectiile cu pneumococ (Streptococcus pneumoniae)
Generalitati

Pneumococul (Streptococcus pneumoniae) este o bacterie din genul streptococilor, care a fost izolat pentru prima data in anul 1881, din sputa, de catre Louis Pasteur, in Franta.
Se gaseste in flora orofaringiana normala la majoritatea populatiei dar poate fi si un important agent patogen uman, fiind principalul agent patogen al infectiilor pneumococice invazive si non-invazive la copii.
Infectiile pneumococice invazive includ pneumonia, meningita si bacteriemia (septicemia); manifestarile non-invazive includ otita medie, sinuzita si bronsita.
Aproximativ 80% dintre pneumoniile bacteriene sunt determinate de pneumococ.
Epidemiologie
Transmiterea se realizeaza pe cale aeriana, directa (prin stranut, tuse, contact cu un purtator asimptomatic), sau indirect prin praf contaminat.
Purtatorii nazofaringieni de pneumococ contribuie la raspandirea infectiei (mai ales in institutiile de ingrijire si in alte spatii comune), avand un rol important in transmiterea tulpinilor rezistente la antibiotice.
Infectia pneumococica are caracter sezonier: in zonele temperate, incidenta atinge nivele ridicate iarna si primavara
Factorii de risc pentru infectia cu pneumococ sunt:
- splenectomia sau disfunctii grave ale splinei
- boli cronice
- imunodeficienta sau imunosupresie (inclusiv toate stadiile infectiei cu HIV)
- varsta, copiii si batranii fiind mai frecvent afectati.
Factorii favorizanti sunt:
- institutionalizarea (risc major pentru transmiterea infectiilor pneumococice rezistente la antibiotice)
apartenenta la un grup socio-economic defavorizat
- poluarea aerului
- expunerea copiilor la fumul de tigara este asociata cu cresterea incidentei otitei medii.
Alaptarea este strans asociata cu scaderea riscului la otita medie in primul an de viata.
Forme clinice
Programează-te rapid la medicii recomandați de SfatulMedicului.ro prin serviciul de programări Clickmed
Găsești peste 7500 de medici cu program disponibil
Alege medicul potrivit pentru: Infectioase .






Streptococcus pneumoniae este agentul etiologic a mai mult de 80% din pneumoniile bacteriene si a numeroase cazuri de otite medii, meningite si septicemii, fiind astfel o cauza importanta de mortalitate si morbiditate.
Pneumonia pneumococica - Simptomele caracteristice sunt: debut brutal, cu febra ridicata (> 39�C), frisoane, tuse, junghi toracic.
In general este localizata la nivelul lobului inferior al plamanului; bronhopneumonia este mai frecventa la copii si varstnici.
In general dupa o terapie cu antibiotice eficienta, vindecarea survine in 2-3 saptamani. Complicatiile sunt rare.
Sinuzita si otita medie - Episoadele de otita medie pot sa apara la orice varsta, dar cel mai adesea in copilarie, mai ales intre 3 luni si 3 ani, in timp ce sinuzitele apar mai frecvent la adulti.
Otita medie acuta este caracterizata de aparitia rapida a simptomelor sistemice sau ale urechii medii, incluzand unul sau mai multe din urmatoarele: otalgie, otoree, febra, iritabilitate, anorexie, varsaturi.
Cea mai comuna complicatie a otitei este pierderea temporara a auzului.
Afectarea grava a auzului poate sa apara dupa episoade repetate de otita.
Articole recomandate
-
 Infectiile streptococice
Infectiile streptococice
-
 Banii: purtatori de bacterii si boli
Banii: purtatori de bacterii si boli
-
 Meningita bacteriana
Meningita bacteriana
-
 Care este cel mai bun colagen pentru articulatii?
Care este cel mai bun colagen pentru articulatii?
-
 Bebelusul sta in sezut? Este posibil sa fie momentul pentru scutecele-chilotel
Bebelusul sta in sezut? Este posibil sa fie momentul pentru scutecele-chilotel
-
 Pneumonia - tipuri si metode de tratament
Pneumonia - tipuri si metode de tratament
-
 Meningita - cauze, simptome, tratament
Meningita - cauze, simptome, tratament
-
 Infectiile urechii
Infectiile urechii
Meningita - Are o rata de mortalitate ridicata. Supravietuitorii unei meningite pneumococice pot ramane cu sechele deosebit de importante.
Sechelele pe termen lung includ deteriorarea auzului, probleme neurologice focale si intarziere mentala.
Bacteriemia (Septicemia) - 3-5% dintre copii cu varsta cuprinsa intre 3-36 luni fara focare aparente de infectie prezinta bacteriemie oculta.
Singurul semn clinic al bacteriemiei oculte este febra.
Bacteriemia oculta poate progresa spre o bacteriemie inalta, care mult mai probabil poate determina complicatii focale sau boala invaziva severa.
La pacientii asplenici se poate produce bacteriemia fulminanta, care poate conduce la coagulare intravasculara diseminata (CID).
Septicemia apare ca o complicatie la 25-30% dintre pacientii cu pneumonie pneumococica si la 80% dintre cei cu meningita pneumococica.
Nu apare de obicei ca urmare a sinuzitelor sau otitelor medii.
Tratament
Terapia antimicrobiana este tratamentul etiologic al infectiei cu pneumococ.
Majoritatea tulpinilor sunt sensibile la penicilina si eritromicina, insa, deoarece s-au semnalat tot mai frecvent tulpini rezistente la penicilina, eritromicina si azitromicina, efectuarea antibiogramei a devenit necesara.
Dozele, calea de administrare si durata tratamentului sunt in functie de forma clinica de boala.
Cu toata eficacitatea antibioterapiei, mortalitatea in cazul infectiilor pneumococice este crescuta mai ales la varstnici si imunocompromisi (splenectomizati, infectati HIV).
De aceea la aceste persoane, se recomanda imunizarea activa prin vaccinare antipneumococica, care asigura o protectie de lunga durata, de pana la 5 ani.
La copiii cu hipogamaglobulinemie sau splenectomizati se recomanda tratamentul cu penicilina orala, deoarece acestia nu raspund foarte bine la vaccinare si fac frecvent infectii pneumococice.
Cu exceptia vaccinarii, nici o alta masura de sanatate publica nu are un impact semnificativ asupra incidentei acestei boli.
Cresterea rezistentei la antibiotice si usurinta cu care se pot raspandi tulpinile rezistente subliniaza importanta controlului prin vaccinare.
Ai o propunere de completare sau neclarități?
In cazul in care articolul nu a acoperit in totalitate un anumit aspect care va intereseaza, va incurajam sa ne trimiteti sugestii pentru completare. Astfel, ne veti ajuta sa completam si sa imbunatatim continutul pentru toti cititorii.
Programează-te rapid la medicii recomandați de SfatulMedicului.ro prin serviciul de programări Clickmed
Găsești peste 7500 de medici cu program disponibil
Alege medicul potrivit pentru: Infectioase .






Articole recomandate
-
 Infectia cu streptococ de grup B
Infectia cu streptococ de grup B
-
 Pneumoniile bacteriene si pneumoniile atipice
Pneumoniile bacteriene si pneumoniile atipice
-
 Cat de periculoase pot fi infectiile cu streptococi?
Cat de periculoase pot fi infectiile cu streptococi?
-
 Ce trebuie sa stim despre alergia la penicilina
Ce trebuie sa stim despre alergia la penicilina
-
 E timpul sa ii ascultam pe parinti! – Studiu al GSK Romania despre impactu ...
E timpul sa ii ascultam pe parinti! – Studiu al GSK Romania despre impactu ...
-
 Caravana medicala „Obezitatea este o boala” aduce evaluari gratuite in P ...
Caravana medicala „Obezitatea este o boala” aduce evaluari gratuite in P ...
-
 Septicemia
Septicemia
-
 Vaccinarea antipneumococica (vaccinare neinclusa in programul national de im ...
Vaccinarea antipneumococica (vaccinare neinclusa in programul national de im ...



 Infectiile streptococice
Infectiile streptococice
 Banii: purtatori de bacterii si boli
Banii: purtatori de bacterii si boli
 Meningita bacteriana
Meningita bacteriana
 Care este cel mai bun colagen pentru articulatii?
Care este cel mai bun colagen pentru articulatii? Bebelusul sta in sezut? Este posibil sa fie momentul pentru scutecele-chilotel
Bebelusul sta in sezut? Este posibil sa fie momentul pentru scutecele-chilotel Pneumonia - tipuri si metode de tratament
Pneumonia - tipuri si metode de tratament
 Meningita - cauze, simptome, tratament
Meningita - cauze, simptome, tratament
 Infectiile urechii
Infectiile urechii
 Infectia cu streptococ de grup B
Infectia cu streptococ de grup B
 Pneumoniile bacteriene si pneumoniile atipice
Pneumoniile bacteriene si pneumoniile atipice
 Cat de periculoase pot fi infectiile cu streptococi?
Cat de periculoase pot fi infectiile cu streptococi?
 Ce trebuie sa stim despre alergia la penicilina
Ce trebuie sa stim despre alergia la penicilina
 E timpul sa ii ascultam pe parinti! – Studiu al GSK Romania despre impactu ...
E timpul sa ii ascultam pe parinti! – Studiu al GSK Romania despre impactu ...
 Caravana medicala „Obezitatea este o boala” aduce evaluari gratuite in P ...
Caravana medicala „Obezitatea este o boala” aduce evaluari gratuite in P ... Septicemia
Septicemia
 Vaccinarea antipneumococica (vaccinare neinclusa in programul national de im ...
Vaccinarea antipneumococica (vaccinare neinclusa in programul national de im ...